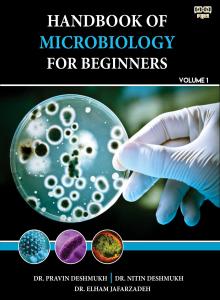
Product image

8% DISCOUNT @300 OR ABOVE (Use Code: DISCTEN)
- View More Coupons...
Popular Categories
- Religion & Spirituality 81
- Self Help, Motivational, Inspirational, Confidence Building & Human Values 78
- Fiction 70
- Educational & Competition Exams 56
- Poetry, Shayari, Gajal, Song 55
- Inspirational 49
- Philosophy 37
- Indian Literature 37
- Social Issue, Economy, Media, Environment & Corporate 33
- Contemporary Fiction 30
- Literature 30
- Literature and Fiction 28
- Non Fiction 28
- Biography & Autobiography 26
- Romance 25
- Motivational 24
- Social Commentary 22
- Language & Linguistic 21
- Hindu Philosophy 20
- Emotional 20
- Academic 19
- Language, Linguistics and Writing 19
- Hindi Literature 19
- Biographies, Diaries and True Accounts 19
- Emotional Poetry 19
- Medical 17
- Poetry 17
- Science, Technology and Medicine 17
- Health & Fitness, Nutrition 17
- Self Help 17
- History 17
- Drama 16
- Health, Family and Personal Development 16
- Short Stories & Articles 16
- Punjabi Book 16
- Love 16
- Women’s Literature 14
- Spiritual Awakening 14
- Fantasy, Horror, Science Fiction, Supernatural 14
- Inspirational Poetry 14
- Contemporary Literature 14
- Psychological Fiction 14
- Cultural Literature 13
- General 13
- Coming-of-Age 13
- Social Issue 12
- Social Fiction 12
- Action and Adventure 12
- Research Work 12
- Exam Preparation 12
- Ayurveda, Herbal Medicine 12
- Alternative Medicine, Traditional and Modern Medicine 11
- Crime, Thriller and Mystery 11
- Education 10
- Punjabi Literature 10
- Literary Fiction 9
- Nursing 9
- Contemporary Romance 9
- Cultural Heritage & History 9
- Art & Culture 9
- Medical Science & Research 9
- Mindfulness 8
- Punjabi Fiction 8
- Devotional Literature 8
- Reference, Scientific reference 8
- Academic Research 8
- Relationships 8
- Inspirational Fiction 8
- Children and Young Adults 7
- Pharmacology 7
- Short Stories 7
- Contemporary Hindi Poetry 7
- Young Adult Fiction 7
- Sikhism 7
- Educational Reference 7
- Indian History 7
- Psychology 7
- Self-Realization 6
- Professional Development 6
- Stock Market, Trading, Banking, Finance 6
- Indian Freedom Struggle 6
- Cultural Studies 6
- Leadership 6
- Higher Education 6
- Botany 6
- Mythology 6
- Anthology 6
- Social Sciences 6
- Textbooks 6
- Art, Film and Photography 5
- Patriotic 5
- Sustainable Development 5
- Indian Religious Texts 5
- English Grammar 5
- Fashion 5
- Personal Development 5
- Romantic Drama 5
- Human Rights 5
- Family & Relationship 5
- Romantic Poetry 5
- Success Strategies 5
- Marathi Literature 5
- Memoir 5
- Agriculture 5
- Environmental Studies, Climate Science 5
- Prayer & Devotion 5
- Punjabi Poetry 5
- Heartfelt Literary Expressions 5
- Patriotic Literature 5
- True Story, True Event 5
- Business and Economics 5
- Vocabulary and Etymology 5
- Computing, Internet and Digital Media 5
- Health & Wellness 4
- Communication Skills 4
- Business Case Study 4
- Mental Health 4
- Sports and Outdoors 4
- Psychiatric 4
- Public Health & Disease Management 4
- Business 4
- Research & Reference 4
- Technology & Engineering 4
- Sikh Heritage & Legacy 4
- suspense 4
- Competitive Exam Preparation 4
- Academic Textbook 4
- Classical Hindi Literature 4
- Human Relationships 4
- English Literature 4
- Yoga 4
- Conscious Living 4
- Sikh Philosophy 3
- Multi-Valued Logic 3
- Healthcare 3
- Human Values 3
- Sikh Theology 3
- B.Sc. Nursing Textbook 3
- Teacher Training 3
- Management 3
- Transformation 3
- Productivity 3
- Computer Science 3
- NTA-NET/JRF/SLET Exam Book 3
- Artificial Intelligence 3
- Mathematics 3
- Literary Theory 3
- Technology & Innovation 3
- Epic Poetry 3
- Supernatural Thriller 3
- Travel and Tourism 3
- Lifestyle 3
- Urdu Books 3
- Rural Literature 3
- Relationship Poetry 3
- Public Policy 3
- Positive Thinking 3
- Parental Love Poetry 3
- Heartbreak Poetry 3
- Meditation & Mindfulness 3
- Historical Fiction 3
- Children's Literature, Inspirational Stories for Kids, Fictional Tales, Illustrated Storybook 3
- Advanced English Language Resource 3
- Literary Criticism 3
- Politics 3
- Real-Life Stories 3
- Mystery 3
- Law, Law Enforcement Training, Cyber Security, Technology & Internet Safety, Legal Studies 3
- Supernatural 3
- Academic Reference & Study Guides 3
- Media 2
- Holistic Wellness 2
- Political & Social Commentary 2
- Teacher Recruitment Preparation 2
- Ancient Texts 2
- UGC NET / SET / JRF Preparation 2
- Space Exploration 2
- Banking 2
- Satire 2
- Gender Studies 2
- Translation 2
- Indian Economy Studies 2
- Economics 2
- Graph Theory 2
- Family Drama 2
- Political Thriller 2
- Feminist & Generational Literature 2
- Discrete Mathematics 2
- Software Engineering 2
- Clinical Research 2
- Terrorism 2
- Anthropology 2
- Medicine 2
- Rehabilitation 2
- Fantasy 2
- Martial Arts & Self-defense 2
- Science Fiction 2
- Social Awareness Literature 2
- Paranormal Fantasy 2
- Cosmology 2
- Dark Fantasy 2
- Future Studies 2
- Gender Equality Literature 2
- Tribal Studies 2
- Young Adult Fantasy Thriller 2
- Historical Non-Fiction 2
- Multidisciplinary Research 2
- Translated Literature 2
- Physical Education 2
- Human Resources 2
- Marathi Poetry 2
- Leaders 2
- Contemporary Marathi Literature 2
- Inspirational Biography 2
- Mindset Transformation 2
- Archaeology 2
- Leadership & Executive Education 2
- Personal Memoir 2
- Military 2
- Philosophical Fiction 2
- Technology 2
- Educational Technology, Teaching 2
- UPSC & Civil Services Preparation 2
- Inner Peace 2
- Construction & Engineering Management 2
- Child Education 2
- Political Science 2
- Science & Consciousness 2
- Friendship 2
- Corporate Strategy in Emerging Markets 2
- Communication 2
- Parenting 2
- Punjabi love poems 2
- Ethics & Moral Philosophy 2
- Faith & Worship 2
- Hinduism 2
- Cybersecurity 2
- Social Justice Fiction 2
- Stress Management 2
- Project Management & Administration 2
- Governance and Democracy 2
- Dalit Literature 2
- Investigative 2
- Space Science 2
- Revenge Drama 2
- Sociology 2
- Sufi Punjabi poetry 2
- Distance Education 2
- Social Impact Studies 2
- Journalism 2
- Current Affairs 2
- Education Psychology 2
- Contemporary Poetry 2
- Study Guide 2
- Patriotism 2
- Educational Transformation 1
- Waste Management 1
- Security & Surveillance 1
- Astrology 1
- Tamil Literature 1
- Multi-Valued Logic (MVL) Systems 1
- Personal Finance 1
- Addiction 1
- Child Skill Enhancement 1
- Government Exam Preparation 1
- Vedic Science 1
- Marketing 1
- Industrial Economics 1
- Young Adult Poetry 1
- Consciousness 1
- Educational Technology 1
- Industrial & Operations Management 1
- Natural Living 1
- Wealth Creation 1
- Dystopian Fiction 1
- Indian Education Policy Studies 1
- Oncology 1
- Abacus Training 1
- War & Soldier Life Poetry 1
- Metaphysical Studies 1
- Consumer Behaviour 1
- Phonetics & Phonology 1
- Gurmat Literature 1
- Android App Development 1
- Mobile Application Programming 1
- Fisheries 1
- Finance 1
- Water Resource Management 1
- Pharmaceutical Science 1
- Prophecy 1
- Business Strategy 1
- Spiritual Fiction 1
- MVL 1
- Investment Strategy Guide 1
- Advanced Electronics Research 1
- Stock Market Investing 1
- Educational Research & Pedagogy 1
- Child Growth 1
- Poetic Love Story 1
- Karma & Reincarnation 1
- Applied Mathematics 1
- Aquaculture 1
- Physics 1
- Medicinal Chemistry 1
- Scriptural Studies 1
- Islamic spiritual book 1
- VLSI & Digital Circuit Design 1
- Financial Education 1
- Sports Biography 1
- LGBTQ 1
- Operating Systems 1
- Sustainable Tourism Guide 1
- Nazm 1
- Women Empowerment 1
- Computational Linguistics 1
- Mathematical Research & Theory 1
- Malayalam Contemporary Novel 1
- Risk Management 1
- Machine Learning 1
- Drug Analysis 1
- Indian Spiritual Heritage 1
- Special Education 1
- Computer Architecture & Logic Design 1
- Trading & Market Psychology 1
- Cricket 1
- Counseling 1
- Apocalyptic Fiction 1
- Civilization Studies 1
- Travel Tips & Destination Insights 1
- Natural Language Processing (NLP) 1
- Student Life Stories 1
- Analytical Chemistry 1
- Dark Romance Fiction 1
- Inclusive Education 1
- Training Resources 1
- Geography 1
- Sports History 1
- Psychotherapy 1
- Indian Financial Services Guide 1
- Cultural Identity 1
- Alien & Space Fiction 1
- Global History of Travel 1
- Civilizational Debate 1
- Parallel Worlds 1
- Narrative Verse 1
- UGC NET English Preparation 1
- Historical Satire 1
- Applied Linguistics 1
- Time Management 1
- Communication Studies 1
- Fish Farming 1
- Midwifery & Maternal Health 1
- Indian Sports Personalities 1
- Behavioral Finance Textbook 1
- Chemistry 1
- Indic Heritage 1
- Time Perception 1
- Espionage Thriller 1
- British Literature Reference Book 1
- Ghost Stories 1
- Language Technology 1
- Destiny 1
- Neuroscience & Psychology 1
- Computer Security 1
- Disability Studies 1
- Social Media Studies 1
- Fisheries Science 1
- Memory Techniques 1
- Gynecology 1
- Magic Fiction 1
- Aryan Discourse 1
- Psychological Sci-Fi 1
- Marathi 1
- Military Memoir 1
- Hindu Scriptures 1
- Medical Laboratory Science 1
- Moral Conflict 1
- Ethical Hacking 1
- Critique 1
- Sociology & Development Studies 1
- Digital Media and Society 1
- Marine Technology 1
- Dictionary 1
- General Knowledge 1
- Defense Techniques & Strategies 1
- Obstetrics 1
- Substance Abuse & Rehabilitation 1
- Political & Revolutionary Literature 1
- Data Analytics 1
- Poems about father 1
- Romantic Science Fiction 1
- Christian Spirituality 1
- Indian Classical Music 1
- Vedic Philosophy 1
- Clinical Pathology 1
- Karma 1
- Mass Communication 1
- Fisheries Management & Sustainability 1
- Professional Communication 1
- Strategic Management 1
- Sikh Martial Art 1
- Critical Analysis 1
- Speculative Fiction 1
- Philanthropy & Leadership 1
- Music Biography & Research 1
- Army Life 1
- Diagnostic Medicine 1
- Redemption Fiction 1
- Astrophysics 1
- Futuristic Language Tools 1
- Foreign Language eBooks 1
- MBA & BBA Textbooks 1
- Defense Studies 1
- Indian Traditional Combat Systems 1
- Spoken English Guide 1
- Transformational Literature 1
- Organizational Behavior 1
- Father tribute book 1
- Climate Change Studies 1
- Musicology & Performing Arts 1
- Indian Defence Literature 1
- Indian Saints 1
- Paramedical & Lab Technician Studies 1
- Indian Armed Forces Literature 1
- Punjabi Health & Wellness 1
- Universe Studies 1
- Applied Biological Sciences 1
- Cyber Law 1
- Science Debate 1
- Humour 1
- Military & Combat Training 1
- Career Development 1
- Chhandaband Kavya 1
- Regional Literature 1
- Digital Safety 1
- Cosmological Thought 1
- Metaphysics & Mysticism 1
- Business English Dictionary 1
- Grammar & Composition 1
- Skill Development 1
- Child Psychology 1
- Corporate & Professional Growth 1
- Punjabi folk poetry 1
- Personality Development & Spiritual Education 1
- Survival Fiction 1
- Music Studies 1
- Information Technology 1
- Mind–Body Health 1
- Professional Development & HR 1
- Reviews 1
- Data Protection 1
- Digital Electronics 1
- Horror 1
- Caste & Culture 1
- CBSE/ICSE/State Board English Guide 1
- Agricultural Competitive Exams Guide 1
- Business Motivation 1
- Indian Cultural Studies 1
- Marriage 1
- Hacking & Network Security 1
- Alternative Healing & Naturopathy 1
- Infrastructure & Nation Building 1
- Gender Issues 1
- Legal Awareness 1
- Computer Engineering 1
- Trading 1
- Cancer Awareness & Prevention 1
- Brain Development 1
- Agriculture Science 1
- Controversial 1
- Self-Improvement 1
- B.Ed. Reference 1
- LGBTQ+ Fiction 0
- Patient Education 0
- Insurance 0
- Singing or Sangeet 0
- Calendars 0
- Records Books 0
- Motherhood Tribute 0
- Comics and Manga 0
- Crafts, Home and Lifestyle 0
- Biblical Teachings 0
- Hindustani Vocal Music 0
- Technical Analysis 0
- School Books 0
- Rebellion 0